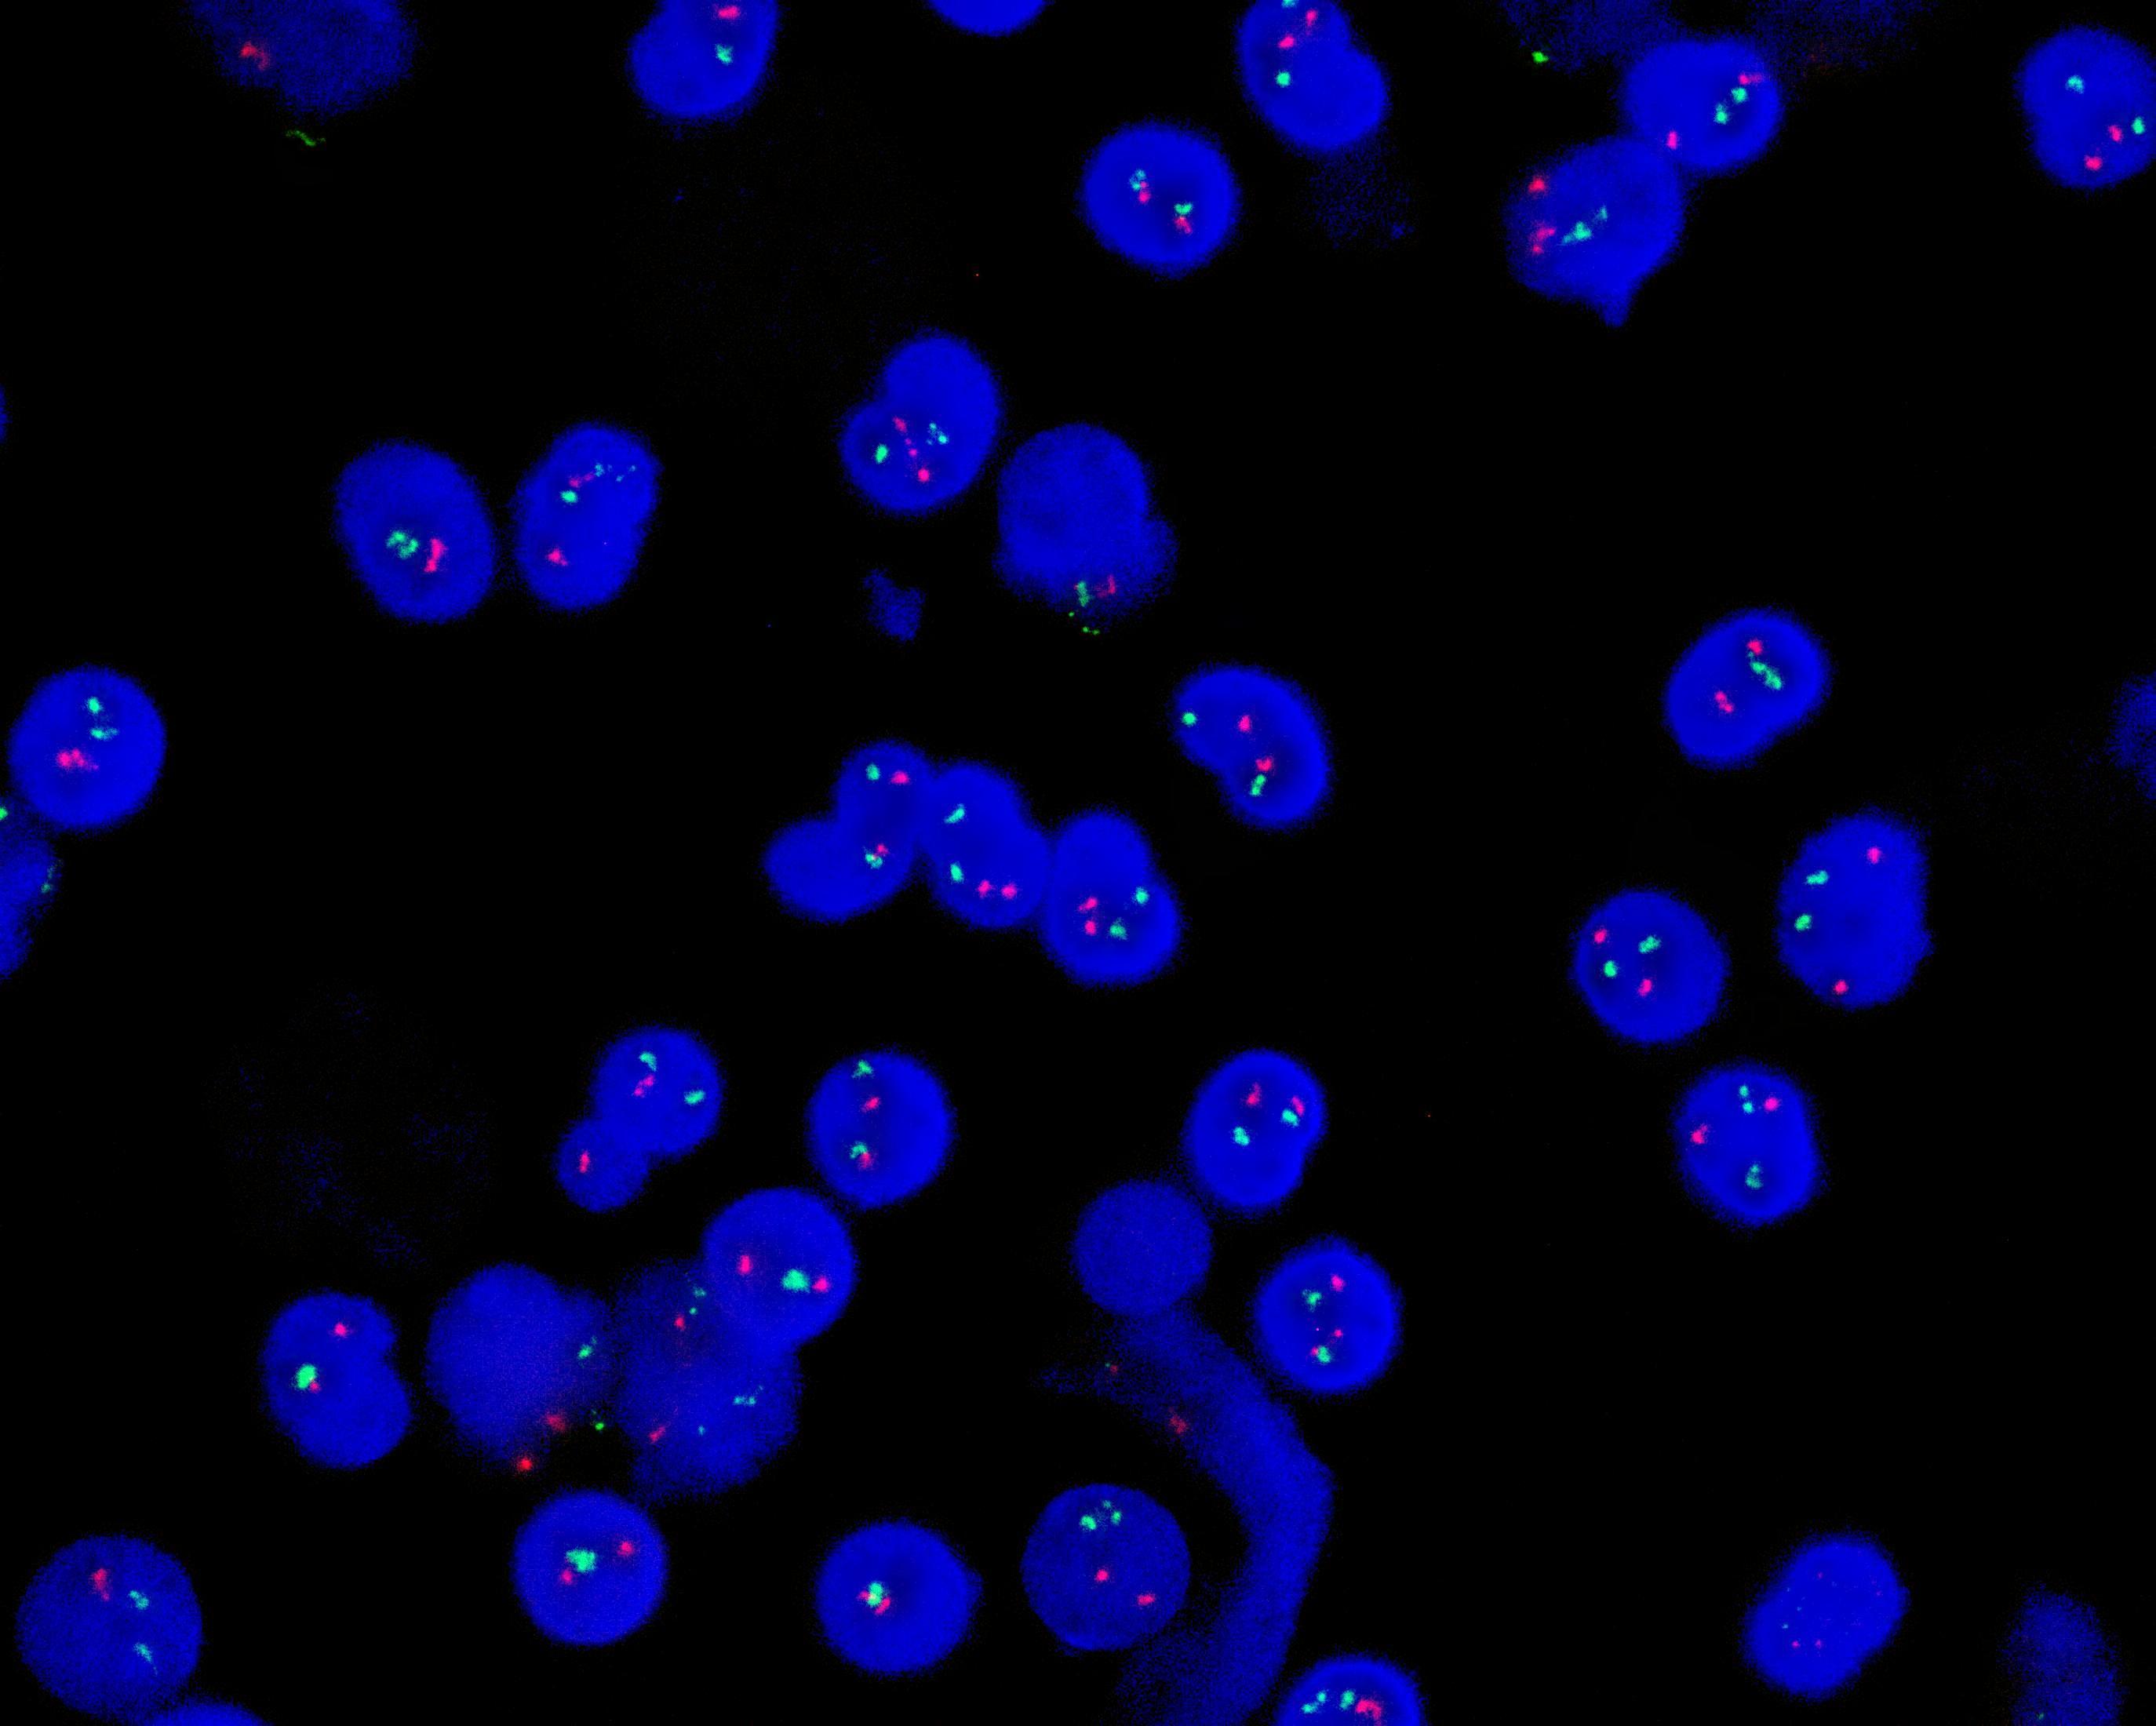
FP-062 -

TCF3/PBX1 gene fusion probe reagent
SKU: FP-062
TCF3/PBX1 gene fusion probe reagent
Regular,in stock
TCF3/PBX1 dual color probe
Description:
PBX1 gene (1q23.3) labeled as orange, with a total length of 605 kb; TCF3 gene (19p13.3) labeled as green, with a length of 931 kb.
Reference:
Garg R, et al. (2009) Cancer 115:2147-2154. Pui CH, et al. (2004) N Engl J Med 350:1535-1548. Bench AJ, et al. (2005) Clin Lab Haematol 27:148-171. Wang Y, et al. (2021) Clin Lymphoma Myeloma Leuk 21:e137-e144.